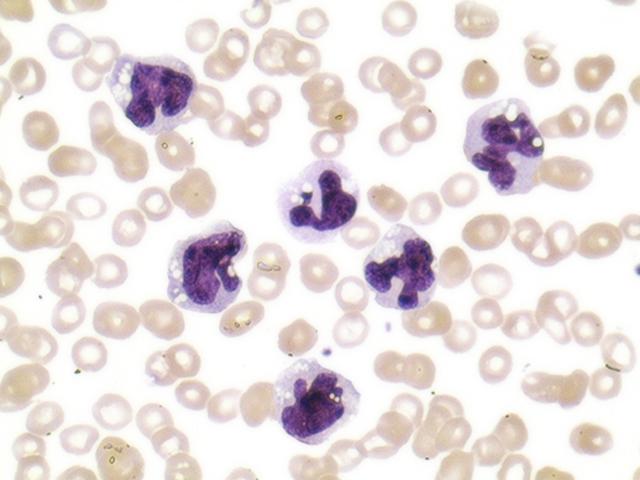
Científicos usan células madre para apurar cicatrización

Científicos usan células madre para apurar cicatrización
Investigadores de la universidad brasileña de Campinas (Unicamp) desarrollaron una técnica inédita con células madre adheridas a hilos de sutura usados en cirugía, que puede revolucionar la medicina de regeneración de tejidos, destacó hoy uno de los responsables del estudio.
"Las células madre, retiradas de los tejidos adiposos (grasas), fueron colocadas en un hilo de sutura común con pegamento de fibrina, un pegamento médico muy resistente y que modificamos para mantener las células vivas durante la aplicación", explicó a EFE el biólogo Bruno Volpe, que desde hace tres años desarrolla el estudio.
Las pruebas hechas con el material consiguieron un 75 % de cicatrización de heridas en tres días y de acuerdo con Volpe las células consiguieron sobrevivir siete días.
La cicatrización es una de las fases más preocupantes después de una cirugía, pues su proceso depende de las condiciones de salud de cada individuo.
La regeneración descubierta por la Facultad de Ciencias Médicas de la Unicamp fue a partir de una fístula intestinal y según Volpe el proceso puede ser realizado en cualquier tipo de heridas, como las que se dificultan para cicatrizar como consecuencia de la diabetes.
La fístula del intestino fue escogida para la investigación por ser un tejido fácil de lesionarse y difícil de cicatrizar.
El proceso fue patentado por la Agencia de Innovación de Unicamp y el próximo paso, adelantó Volpe, es el de mejorar el tiempo de vida de las células madre hasta unos quince días, para poder exportar la técnica a otros países.
"Antes de eso, la expectativa es la hacer viable el uso del método en la red pública de salud de Brasil para disminuir el tiempo de internación de los pacientes, lo que significa un menor gasto público y una mayor calidad de vida al paciente", resaltó el biólogo.
El proyecto busca asociaciones para financiar más inversiones y que la técnica consiga una mayor difusión, pues en la actualidad el procedimiento sólo es realizado en pacientes de la universidad.
Las pruebas iniciales fueron practicadas con ratones de laboratorio, en los que las células madre regeneraron casi todo el tejido del intestino de los roedores.
El tiempo de recuperación de las fístulas por medio del tratamiento convencional en los ratones es equivalente al organismo humano, con unas diez semanas.
Desde la década del setenta, cuando a medicina descubrió la existencia y la capacidad de las células madre, los investigadores buscan formas de aprovechar su potencial.
La aplicación directa de las células madre no da el mismo resultado "milagroso" que el hilo de sutura enriquecido, destacó Volpe.
Una investigación española, usada como referencia por los brasileños, probó el efecto de las células madre directamente en la herida, pero sin los resultados de cicatrización conseguidos ahora con la nueva técnica que usó un hilo de treinta centímetros.
En Estados Unidos, en tanto, fueron ensayados otros tipos de hilos para ayudar en la cicatrización, pero no se tuvo en cuenta las células madre.
El estudio indicó que el procedimiento no exige pruebas de compatibilidad para la adhesión de las células en los pacientes y no hay señales de inflamación o rechazo en el organismo en el que las células fueron aplicadas.
Esa línea de investigación de la Unicamp surgió en 2005 a partir de aulas de cirugía plástica, en las que el cirujano Ithamar Stocchero evaluó el uso de células madre en hilos de sutura.
"Esto muestra que Brasil tiene condiciones de producir ciencia igual o mejor que en otros países", puntualizó Volpe.
Fuente: EFE.
Foto: Flickr/galibo.